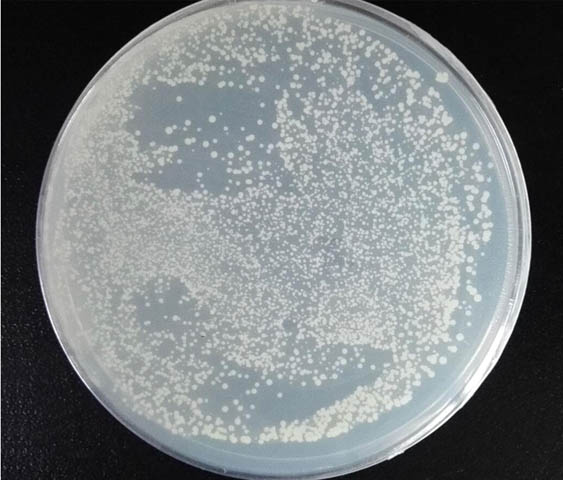

【優(yōu)惠促銷】快捷型酵母高效感受態(tài)制備試劑盒
發(fā)布者:莊盟生物發(fā)布時間:2022-02-25瀏覽次數(shù):2145次
快捷型酵母高效感受態(tài)制備試劑盒
◆可長期保存 ◆ 簡單易操作 ◆ 轉(zhuǎn)化效率高 ◆ 性價比高
促銷截止時間:2022年4月30日
貨號 | 名稱 | 規(guī)格 | 目錄價 | 促銷價 |
ZC135-1 | 50T(50支) | 498 | 398 | |
| ZC135-2 | 100T(100支) | 798 | 638 | |
| ZC135-3 | 200T(200支) | 1298 | 1038 |
◆ 產(chǎn)品特點 ◆
1.轉(zhuǎn)化效率高
可達(dá)105-106 cfu/μg DNA,可以滿足酵母雜交實驗,以及酵母文庫構(gòu)建實驗。
2.可長期保存
制備的酵母感受態(tài)細(xì)胞可-80℃長期凍存至少6個月,無需多次重復(fù)制備。
3.簡單易操作
制備過程:搖菌后10min即可完成酵母感受態(tài)細(xì)胞制備。
轉(zhuǎn)化步驟:特有的單鏈擔(dān)體鮭魚精DNA已經(jīng)混合進(jìn)轉(zhuǎn)化試劑里,無需每次繁瑣的重復(fù)處理;即開即轉(zhuǎn),省時省力。
4.性價比高
單支成本低至5.2元/支。
注解:500ng PGADT7 轉(zhuǎn)化 50μl 感受態(tài)





